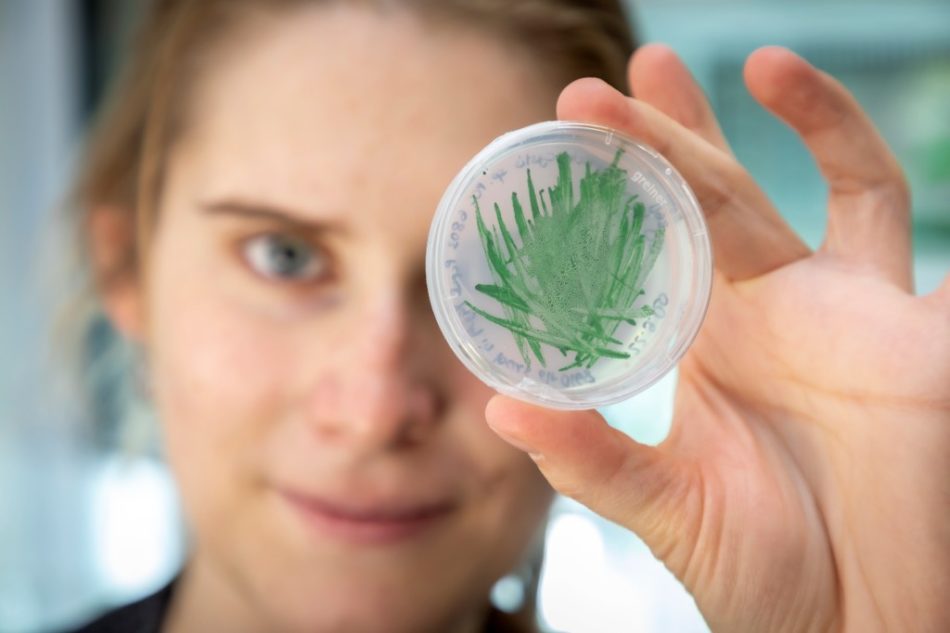

Blaualgen als Katalysatoren in der Biotechnologie
Foto: Lunghammer/TU Graz
Blaualgen oder Cyanobakterien, wie Fachleute sie nennen, könnten bei der biotechnologischen Produktion von Chemikalien nützlich sein. Für ihr Wachstum benötigen sie alle Wasser und Kohlendioxid. Forschende der TU Graz und der Ruhr-Universität Bochum zeigen, wie sich deren katalytische Aktivität steigern lässt.
Im Volksmund heißen sie Blaualgen, Experten sprechen von Cyanobakterien. Sie wandeln Lichtenergie in ihren hochaktiven photosynthetischen Zellen besonders effektiv in chemische Energie um und sind deshalb für einen Einsatz in der Biotechnologie hoch interessant. Dort könnten sie als umweltfreundliche Biokatalysatoren zur Herstellung neuer Chemikalien eingesetzt werden.
Knackpunkt bei dieser Sache ist allerdings, dass die gesamte Bakterienmasse viel Licht benötigt. Das limitierte bisher eine praktische großtechnologische Umsetzung. „Wenn Cyanobakterien dicht gewachsen, also hoch konzentriert sind, dann bekommen nur die außen angesiedelten Zellen genug Licht. Innen ist es ziemlich dunkel“, erklärt Robert Kourist vom Institut für Molekulare Biotechnologie der TU Graz.
Produktivität nimmt ab, wenn das Substrat nicht gut beleuchtet wird
Das bedeutet auch, dass die Katalysatormenge nicht beliebig gesteigert werden kann, denn die photosynthetische Aktivität und damit die Produktivität der Zellen nimmt ab einer Zelldichte von wenigen Gramm pro Liter stark ab. „Das ist natürlich für die biotechnologische Großproduktion ein erheblicher Nachteil“, sagt Kourist.
Verglichen damit können etablierte Biokatalysatoren wie etwa Hefen mit Zelldichten von 50 g/l und sogar noch darüber hinaus genutzt werden. Allerdings haben sie auch den Nachteil, dass sie landwirtschaftliche Produkte als Nahrungsgrundlage benötigen und damit Ressourcen verbrauchen. „Algenbasierte Katalysatoren können aus Wasser und CO2 herangezogen werden, sind also in doppelter Hinsicht ‚grün‘. Daher gibt es intensive Bemühungen, die katalytische Performance von Cyanobakterien zu erhöhen“, so Kourist.
Photosynthetischer Elektronenfluss umgeleitet
Nun ist es den Grazer Forschenden gemeinsam mit Teams der Ruhr-Universität Bochum und der finnischen Universität Turku gelungen, diese katalytische Performance zu steigern. Dafür wurde der photosynthetische Elektronenfluss gezielt in die gewünschte katalytische Funktion umgeleitet. „Wir konnten erstmals die Bereitstellung photosynthetischer Energie direkt in den Zellen zeitaufgelöst messen, sodass wir darüber Engpässe im Metabolismus identifizieren konnten“, erklärt Marc Nowaczyk vom Lehrstuhl für Biochemie der Pflanzen an der Ruhr-Universität Bochum.
„Daher haben wir im Genom des Cyanobakteriums ein System ausgeschaltet, das die Zelle vor fluktuierendem Licht schützen soll. Dieses System ist unter kontrollierten Kultivierungsbedingungen nicht notwendig, verbraucht aber photosynthetische Energie. Energie, die wir lieber in die Zielreaktion einbringen“, erläutert Hanna Büchsenschütz, Doktorandin an der TU Graz und Erstautorin der Studie.
Wegen der hohen Zelldichten von Cyanobakterien konnte so die Ausbeute verbessert werden. „Anders gesagt: Wir können nur eine gewisse Menge an Zellen einsetzen. Deswegen müssen wir die Zellen schneller machen. Und dafür haben wir über das sogenannte Metabolic Engineering einen Weg aufgezeigt, der Cyanobakterien einen großen Schritt reifer macht für die biotechnologische Anwendung“, sagt Kourist.
Neue Konzepte für die Algenkultivierung
Nicht nur durch Eingriffe ins Genom, sondern auch durch Verbesserungen des Kultivierungsprozesses lässt sich die Produktivität der Algen steigern. So lassen sich Lichtquellen wie zum Beispiel Mini-LEDs direkt in die Zellsuspension einbringen oder es wird mit neuen Geometrien experimentiert. In Form abgekapselter kleiner Kügelchen können Cyanobakterien möglicherweise Licht aufnehmen. Kourist: „Es ist ganz wichtig, alle Maßnahmen auf dem Weg zur großindustriellen Anwendung von algenbasierten Biokatalysatoren integriert zu entwickeln. Das geht nur mit interdisziplinärer Forschung, die die Funktionsweise eines Enzyms genauso betrachtet wie das Engineering in der photosynthetischen Zelle.“












